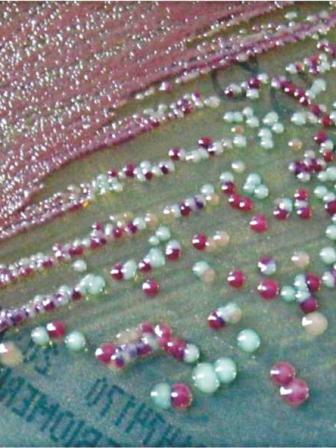
finding_the_superbug_1.jpg

Post-partum diet

A healthy postpartum diet can help heal and boost energy levels during those sleep-deprived days. Every woman's nutrition needs are different and depend on many factors. Losing those pregnancy pounds might be at the top of their minds over nourishing their body with the right foods to support recovery, milk production, rest, and all the other tasks required to get through the day. Plus, if any health condition like diabetes is also present, one may need to follow a different dietary pattern in order to optimise blood sugar control.
Here are some tips to follow:
l If one is trying to lose weight while breastfeeding, a slow weight loss of 1 pound per week or 4 pounds per month is ideal. For some women, breastfeeding helps them lose baby weight more quickly than non-breastfeeding mothers. Weight loss seems to increase after the 3-month mark. Others may notice increased fat stores on their hips or legs until breastfeeding stops. This is likely because breast milk draws from lower body maternal fat stores in order to support infant brain development.

l Breastfeeding moms are especially at risk for energy-draining dehydration. Up to 3 litres of water daily is recommended. A good way to gauge hydration is looking at the colour of urine. Juice and milk are very good options. But caffeinated drinks like coffee or tea need some careful attention. Have no more than 2-3 cups a day because it can stimulate dehydration.
l Exclusively breastfeeding women require approximately 400 to 500 additional calories per day. However, individual calorie needs are highly variable and depend on body size, age, activity level, and how much you are breastfeeding.
l Aim to minimize snack foods and items that are high in added sugar, sodium, and saturated fat, including fried foods, soft drinks, and desserts.
l Nursing moms need to eat extra protein and vitamin B-12. Lean beef is an excellent source for both. Eggs and fatty fish are excellent sources of protein and healthy fats, while vegetables, whole grains, and fruits provide fibre-rich carb sources. Nuts, seeds and full-fat yoghurt are more examples of healthy fat sources. Not only are these foods a great source of protein, fat, and carbs, but they are packed with vitamins, minerals, and antioxidants that help promote overall health.
l Eat foods rich in nutrients like vitamin C, zinc, and selenium to help keep immune system strong.
l DHA is crucial to the development of baby's nervous system. All breast milk contains DHA, but levels of it are higher in the milk of women who get more DHA from their diets through sea fishes.
l Leafy green veggies like spinach and broccoli are filled with vitamin A, which is good for both mother and baby. The benefits don't stop there. They're a good non-dairy source of calcium and contain vitamin C and iron. Also focus on foods with insoluble fibre, like bran cereal, nuts, beans and potatoes. Insoluble fibre moves through the intestines intact, creating bulk and preventing constipation. Drinking plenty of water will help prevent all that fibre from backing up rather than helping you go, and will help replenish fluids lost during birth.

l If all looks good at six weeks, one can start exercising with walks, light stretching and different breathing techniques. Exercise is great for mood and energy levels and can give mothers a mental break and some 'me time' that they truly need.
l Some foods are often great sources of nutrients that breastfeeding mothers need anyway: oatmeal (carbohydrates, fibre and iron), black cumin seed, chia and flaxseed (fibre, calcium and omega-3s), barley (fibre, protein, B vitamins and iron) and dates (iron, fibre, calcium, B vitamins and vitamin C).
l It's estimated that 1 in 5 women go into pregnancy iron-deficient and may stay deficient throughout their pregnancy, so load up on iron-rich foods. Liver, beef, legumes and spinach are all good sources. Vitamin C can help increase that absorption, so add vitamin C-rich foods like lemon juice, orange or country fruits in the meal.

l The sun is the best source of vitamin D so going outside for a walk is very important.
l Like vitamin D and omega-3s, iodine passes through breast milk to the baby. So, if the mother is deficient in iodine, the baby could also become deficient. Iodized table salt is the easiest way to incorporate into the diet.
The quality of breast milk stays pretty much the same. But there's a catch: When one cannot get the needed nutrients from their diet, the body will provide them from own stores. So it's important to make sure the nutrition supplies required for breast milk are constantly supplemented by the diet. Routinely eating healthy foods throughout the day will maximize the little energy one probably have as a new mom.
Photo: LS Archive/Sazzad Ibne Sayed



 For all latest news, follow The Daily Star's Google News channel.
For all latest news, follow The Daily Star's Google News channel.
Comments